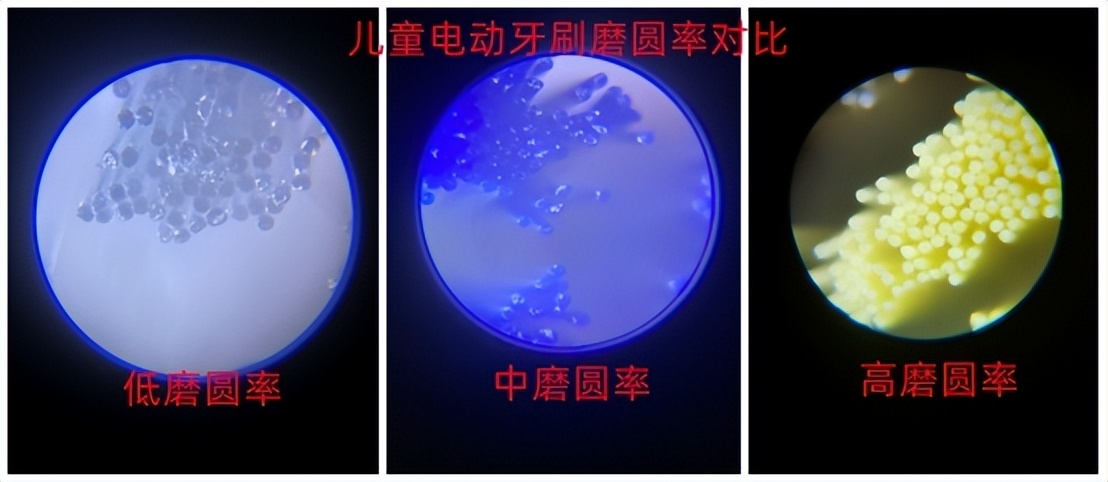
儿童电动牙刷有没有危害？五类伤牙坑货不要选

作为一名口腔护理师,宋明在网上时常能刷到“儿童电动牙刷伤牙”的帖子,那么宝宝、小孩子、小朋友用儿童电动牙刷有没有危害?为了给各位家长一个全面的科普,我通过测评市面上常见的数十款儿童电动牙刷,以及自身的专业所学,为大家总结了它的伤牙危害和优点好处,所以今天这篇科普文大家一定要看!
下图是我测评过的部分儿童电动牙刷:

一、儿童电动牙刷的危害副作用科普
儿童电动牙刷有没有危害?孩子的口腔正在生长发育中,而且现在孩子龋齿率高达70%,所以要给孩子选择安全、清洁力强的清洁工具才是最优选择! 因为不论是手动牙刷还是儿童电动牙刷,如果使用不当,或者孩子刷牙方法不对,同样也会造成牙齿损伤。 在此,我特别为大家总结一下儿童电动牙刷的三大危害:

危害1:牙齿牙龈频繁流血。 现在市面上有不少以“网红大牌”为名的儿童产品,其中有不少都存在刷头类型少、刷毛硬、磨圆率低、材质低劣、震动区间狭窄等问题。这一类的产品一旦被孩子们使用,会引起牙龈出血、牙釉质受损等问题。很多被坑的家长们纷纷吐槽这些坑货(如下图):

危害2:牙齿受到磨损。 从工作原理上我们知道,电动牙刷是利用机芯马达产生的高振动频率,从而带动刷头对牙齿进行清洁,但如果产品震频太高或者刷毛太硬就会造成牙釉质过度磨损伤牙。
危害3:诱发慢性伤牙危害。 一些知名品牌,也开始涉足儿童电动牙刷领域,但大部分产品,都是找工厂代工,没有自己的技术和研发,甚至连儿童产品都做不出来,直接用成人电动牙刷替代儿童电动牙刷!这些产品可能会对牙齿造成长期的伤害,而且这种损伤是不可逆的,一般要等到一年或者半年以后才会发现。
二、五类千万不能买的坑货产品
儿童电动牙刷有没有危害?市场上儿童牙刷产品种类繁多,商家的营销也是花样百出,其中不专业的产品确实存在伤牙风险。家长们买东西时稍不留神就容易中招。为此我给大家总结了五类常见的商家套路产品,希望家长们在购买的时候可以避开:
1、不支持试用的产品不要选择。 建议大家要首先选择支持可以试用的产品。产品收到了,先让孩子入口体验一下,看看孩子是不是喜欢用!支持试用,无理由退换,这种产品能保证我们假如买到不适合产品,方便随时退换,降低翻车概率。
2、不要选择靠广告流量、网红带货的品牌。 网络上有不少这样的品牌都是来割韭菜的。产品本身根本没有考虑孩子的口腔特点,一味地控制成本,有的甚至不到60元,售价200-300元甚至400多块,各种广告,流量明星代言,用漂亮的外观设计来吸引女性消费者的关注。但实际上,由于这种产品价格低、质量差,不能有效地清洁牙齿和牙龈。

3、不要选择号称性价比高,实际上质量低劣的产品。 市面上一些打着性价比高,或者喜欢打价格战的儿童电动牙刷,其原材料多数都是价格便宜的,并且加工工艺也非常简陋。例如:刷柄、刷头表面处理粗糙,刷毛不平整,磨光度不高;电机多为便宜的空心电机,振动不均匀、不稳定,不但不能达到牙齿保养的目的,而且会对儿童牙齿造成严重损害。

4、不要选择兼容性差的产品。 上文有数据显示,我国儿童口腔环境是龋齿等牙病高发状态。一支专业的电动儿童牙刷,必须在频率、功率范围、刷毛等方面具备兼容性,但是一些不专业的牙刷往往存在档位少、震频范围窄、刷头种类少等现象,所以很多电动牙刷,哪怕是几千块钱,也会对孩子的牙齿造成伤害。

5、不要选择跨界大牌贴牌产品。 别看有的品牌知名度很高,实际上最开始并不属于儿童电动牙刷行业,只是厂家想要赚钱一波快钱而已。这类产品只注重提高马达的震频、色彩、耐久性、防水性能,却没有投入更多的精力去研发儿童电动牙刷的护龈护牙体验、人群适应性、频率范围、摆动角度、功率范围等等功能。这类产品根本经不起市场的考验,家长们千万不要踩坑。
三、如何避免伤牙?家长必读7个妙招
儿童电动牙刷有没有危害?通过上文的分析可以知道儿童电动牙刷确实存在一定的伤牙风险,但是只要选择专业和优质的产品,儿童电动牙刷即可以有效清洁牙齿,也不会伤到牙齿。根据测试结果,我总结出了7条选购规则来帮助家长避免购买雷区:
1、刷毛的磨圆率要在80%以上。
建议选择磨圆率在80%以上的产品,磨圆率数值越高越能保护牙齿,所以家长要尽可能选择磨圆率高的儿童电动牙刷,以免伤牙。
2、注重品牌的专业技术实力
优质的儿童电动牙刷品牌往往有着多年的儿童口腔护理经验,也会针对孩子的口腔需求做相关技术研发,比如说震频范围、摆幅角度、磨圆率等都适配孩子的需求,有了硬实力产品才能高效清洁不伤牙。
3、刷头种类要丰富
一般的儿童电动牙刷要给孩子用几年的时间,有些甚至说可以3-15岁使用,而孩子成长速度快,不同阶段对刷头选择不同,所以那些只有1-2个刷头可选择的产品就不要选了,压根不能满足孩子的口腔需求,要选择有多种刷头匹配的产品。

4、刷毛的软硬度要适合孩子
这个点就关乎清洁力和护牙率了,太硬的刷毛容易伤牙、太软的刷不干净,要根据孩子的实际情况选择,比如说小龄儿童用较软的刷毛,保护口腔,大龄孩子要使用适中偏软的刷毛,有清洁力也舒适。

5、选续航时间长的
续航时间长用着比较方便,不用频繁充电,建议选择续航30天的产品,这也意味着电池的质量更好。一些产品电池质量较差,一般使用几天就要充一次电不实用。
6、刷头的摆幅最好是在3-6度以内。
我国儿童的口腔素质较差,耐受度也不高,那么选择儿童电动牙刷的摆幅就不能太高,否则很容易会伤牙,但是太低的话,想要的清洁效果又达不到,所以儿童电动牙刷科学的摆幅范围是控制在3-6度以内,能有清洁力又不伤牙。
7、震频范围一定要足够大
儿童电动牙刷要用个几年的时间,这阶段孩子都在发育,成长速度快口腔变化大,一定要选择震频足够宽的,才能根据不同阶段的需求随时调整,如果震频范围窄,没用多长时间就不适合了。
市场上普遍存在很多不专业的品牌大肆宣传不伤牙、清洁力强等优势,实际使用效果却差强人意。 对于家长们来说,从五花八门的产品中,选择较为专业的儿童电动牙刷很是困难。所以家长们一定要擦亮眼睛,不可被市场中一些花里胡哨的宣传误导,而买到伤牙产品。以下是16款儿童牙刷清洁力及舒适度测试数据,涵盖儿童电动牙刷以及手动牙刷,我也结合自己的测评经验,推荐几款专业产品给大家参考:

过去评测的大量儿童电动牙刷品牌中,我认为 扉乐VIIV 是综合表现和专业调校最好的。 国内唯一专业护龈护牙品牌,被媒体誉为容错率高的儿童电动牙刷,哪怕孩子有概率错误刷牙也不伤牙! 他们家儿童电动牙刷 高效清洁下降低90%摩擦伤害! 他们第一个针对儿童不同阶段 打造“六型分段护理” ,震频和动力跨度非常大,能够兼容不同儿童阶段,打造多种刷头匹配不同儿童牙齿阶段, 尤其是特有的万毛绵柔刷头,将安全不伤牙做到了极致! 他们还针对振动频率、动力、摆幅、刷毛等百余项参数多年技术调校,在3-5年内各项调校指标的偏差值不高于0.1%,且针对不易察觉的慢性伤牙做了特殊优化。从不做广告,不搞网红带货,主要是得到众多牙医推荐!作为众多品质榜单的常客,比起很多品牌拼颜值,比低价,它所拥有的理性、专注、专一的品牌特质,把电动牙刷当严谨医学研发我很认可!
另外 飞利浦还可以,整体震感和动力很强,摆幅角度也较大。 作为欧美品牌,专为欧美人群牙齿设计,对国内复杂的牙齿特征兼容性稍差,有概率性伤牙。
如果追求性价比,低价产品中可以看看拜尔和舒客 ,基础配置参数和功能还算过关,但是品质和性能表现中规中矩跟专业的肯定没法比,1年质保,刷头20元左右一支。
飞利浦不支持试用,而且它的刷头较贵,一年需要150元左右,扉乐支持试用,而且最近限时赠送5年刷头,累计可节省大几百元。

四、儿童电动牙刷有伤牙风险,牙医还推荐吗?
儿童电动牙刷有没有危害?现在提倡孩子使用儿童电动牙刷已经成为当下的趋势,所以给孩子用儿童电动牙刷到底有哪些好处?
如今中国儿童龋齿率高达70%(如下图),而使用专业的清洁工具,才能更好地起到清洁口腔的作用,同时也可预防蛀牙的发生。所以牙医更推荐4岁以上孩子使用儿童电动牙刷,相比手动牙刷,儿童电动牙刷的好处还是很多的,我给大家总结了以下五个方面:

好处1:清洁力更强,有效防止蛀牙。 儿童电动牙刷清洁力比手动牙刷强数十上百倍,能有效清除牙菌斑,帮助儿童清理牙龈沟、牙缝、齿背等牙病高发部位,预防龋齿,保护口腔健康。

好处2:震频均匀稳定,力度更精准。 儿童电动牙刷的频率振动是稳定且均匀的,不容易出现因用力过猛而造成的牙龈损伤等情况。儿童使用手动牙刷,很难掌握,如果力度过大的话会造成牙龈损失,而过小的话清洁效果会不理想。
好处3:使用起来无门槛,好掌握。 10岁以下的儿童无法熟练使用手动牙刷刷牙,刷牙方式及力度也不能熟练掌握,因此很难自行清洁。儿童电动牙刷使用起来更加方便,降低孩子刷牙门槛,更好掌握。
好处4:省时省力。 儿童电动牙刷震动频率清洁牙齿,省时省力,仅用2分钟即可达到手动牙刷清洁十分钟。时间短,不考验孩子的耐性,孩子们也爱用。
好处5:让牙齿更洁白,为个人形象加分。 使用专业儿童电动牙刷可容易刷干净牙齿,有效去除牙渍和细菌,可使宝宝口气清新,远离口臭,使牙齿更洁白、更自信。
儿童电动牙刷有没有危害?现在众多牙医是建议4岁及以上孩子应该使用儿童电动牙刷。我作为口腔师,提醒家长们给自家宝宝、小孩子、小朋友选购儿童电动牙刷的时候,一定要先考虑品牌实力过硬的产品,不仅好用而且兼容性好,用起来更安全,而那些网红产品或者只有1到2个档位的产品就没必要考虑了。